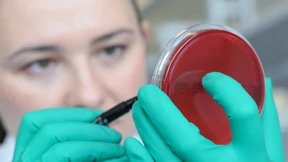
Innovative Krebstherapien

Etwas ist faul in dieser Koalition
Die Koalition ist mit dem Anspruch angetreten, der Realität ins Auge zu blicken. Aber wo tut sie das? Die Beispiele Wehrpflicht, Rente und Klima zeigen: Sie weicht ihr aus.

Die Koalition ist mit dem Anspruch angetreten, der Realität ins Auge zu blicken. Aber wo tut sie das? Die Beispiele Wehrpflicht, Rente und Klima zeigen: Sie weicht ihr aus.

Fast die Hälfte der Deutschen beklagt, dass man seine Meinung nicht mehr frei sagen könne. Doch ihr eigenes Verhältnis zur Freiheit ist widersprüchlich.

Der ukrainische Präsident ist abermals zu Gast im Weißen Haus. Altkanzler Schröder muss sich zu den Nord-Stream-2-Geschäften äußern. Und die Bahn stellt einen neuen ICE vor. Der F.A.Z. Frühdenker.

Die Regierung will Elektroautos attraktiver machen. Aus der SPD kommt nun ein konkreter Vorschlag, wer wie bezuschusst werden könnte. Doch welche günstigen Modelle gibt es eigentlich? Ein Überblick.

Donald Trumps „Department of Government Efficiency“ zeigt, wie radikale Verwaltungsreformen aussehen können. Für Deutschland stellt sich die Frage: Vorbild oder Warnung?

Wie der Tumor selbst den Weg zur möglichen Therapie weist: Professor Thomas Seufferlein, Vorstandsmitglied der Deutschen Krebsgesellschaft, spricht im Interview über Chancen, Grenzen und Zukunftsperspektiven der personalisierten Krebsbehandlung.

Vor 20 Jahren starb bei vielen Krebserkrankungen weit über die Hälfte der Patienten. Heute kann Krebs in vielen Fällen therapiert oder sogar geheilt werden. Durch Prävention und Früherkennung könnte zudem mehr als die Hälfte aller Todesfälle verhindert werden.
Krebs ist und bleibt eine der größten medizinischen Herausforderungen. Doch neue, spezialisierte Therapien, die sich an den individuellen Eigenschaften von Patient und Tumor orientieren, eröffnen echte Chancen.

Enamullah O. hat am 22. Januar in einem Park zwei Menschen erstochen, darunter ein Kleinkind. Vor Gericht wirkt der Täter gleichgültig. Das sei Zeichen seiner Krankheit, sagt die Verteidigung.

Zum ersten Mal dürfen Richter prüfen, ob die Öffentlich-Rechtlichen wirklich vielfältig genug sind. Kommt jetzt die große Klagewelle gegen ARD, ZDF und Deutschlandradio?

Immer mehr Neuntklässler erfüllen die Mindestanforderungen in Mathematik und Naturwissenschaften nicht. Auch an Gymnasien. Das zeigt der IQB-Bildungstrend.

Wie wird der Schlaf erholsam? In dieser Mission ist die Bettfedernfabrik Otto Keller unterwegs. Worauf es bei Federn, Decken und Daunen ankommt.

Bad Nauheim zählt in Deutschland zur Spitzengruppe im Smart-City-Ranking. Mit einem neuen KI-Angebot auf der Homepage festigt die Kurstadt ihren Ruf. Zumal es als Pilotprojekt für Deutschland gedacht ist.

In einer Stadt im Münsterland treten ein Manager und ein Beamter an, die digitalste Stadt des Landes zu erschaffen. Was entsteht, wenn Tech-Visionen auf den deutschen Verwaltungsalltag treffen?

Es geht um das Zurückdrehen der Uhr: Die internationale Alternsforscherin und Ärztin Andrea Maier spricht über ihre Longevity-Kliniken, digitalisierte Patienten, Nahrungsergänzungsmittel und regulatorische Hürden.

In einer pfälzischen Kleinstadt versuchte Horst Stowasser frei von Regeln und Herrschaft zu leben. Heute steht dort ein großes anarchistisches Archiv. Ein Ortsbesuch.

Die Ampelregierung hat Cannabis verharmlost. Auch Schwarz-Rot ignoriert den sofortigen Handlungsbedarf für vulnerable Jugendliche und Schwangere.

Bio-Verbände und Verbraucherschutz bewerten das geplante Verbot von Namen wie „Veggie-Schnitzel“ überwiegend kritisch. Bauern und Metzger halten dagegen.

Wer eine Immobilie zur Kapitalanlage zum Vermieten sucht, wird jetzt wieder fündig. Wo sich der Kauf einer Wohnung oder eines Hauses aktuell besonders anbietet.

Besonders verbreitet in Deutschland ist derzeit die Linie Stratus. Die Inzidenz liegt laut RKI derzeit bei 600 Erkrankungen pro 100.000 Einwohner. Und auch andere Viren gehen um.

Dem Wolf wird in ganz Deutschland ein „günstiger Erhaltungszustand“ attestiert. Das freut den hessischen Landwirtschaftsminister. Er sieht darin einen entscheidenden Schritt auf dem Weg zur legalen Bejagung. Naturschützer üben Kritik.

CDU-Generalsekretär Linnemann will aus dem Konrad-Adenauer-Haus eine moderne Denkfabrik machen. Aber hat die Partei so etwas nicht längst?

Der Vertrag zwischen der EU und Indien rückt näher. Welche Hürden noch zu nehmen sind, erklärt ein Wirtschaftsjurist von Rödl & Partner.
Was als Woche eines unglaublichen Friedensversprechens im Nahen Osten begann, setzt sich mit wachsenden Konflikten zwischen Peking und Washington fort. Für Deutschland und Europa kann das nur heißen, ihre Neuaufstellung noch rascher und druckvoller voranzutreiben.

Im Bundestag ringt die Koalition um den Wehrdienst und die Rente. Die EU-Kommission legt ihren Aufrüstungsfahrplan vor. Und: Julia Roberts im Kino. Der F.A.Z.-Frühdenker.

Die japanische Modemarke Uniqlo eröffnet am Donnerstag ihre neue Vorzeigefiliale in der Frankfurter Innenstadt. Die Ausstattung ist edel und es gibt viele Service-Extras.

Ist die Branche hierzulande wettbewerbsfähig? Daran zweifeln viele Unternehmen. Die Bundesregierung will mit einer Mikroelektronik-Strategie das Ruder herumreißen.

Weder der Pistorius-Vorschlag noch der Röttgen-Plan zum Wehrdienst wird der Lage gerecht. Die Koalition verheddert sich in einem unproduktiven Streit.

Das Prüfungs- und Beratungsunternehmen EY will den Wirecard-Bilanzskandal hinter sich lassen. Doch internationale Klagen und eine langsame deutsche Justiz überschatten die Rehabilitation.

Im historischen Stadion „The Oval“ müht sich die U 21 zum Sieg. Zuvor hatte Julian Nagelsmann den Hype um zwei Talente einkassiert. Über einen doppelten Realitätscheck für einen ordentlichen Jahrgang.

Es sollte eigentlich einen Kompromiss zum Wehrdienst geben, aber vor allem Verteidigungsminister Pistorius (SPD) hatte Einwände. Droht jetzt eine Koalitionskrise?

Dänemark ist Vorbild für den Plan, per Los Wehrpflichtige zu bestimmen. Doch tatsächlich erfolgt der Wehrdienst dort bisher ohne Zwang. Wie funktioniert die Musterungs-Lotterie?

Instagram orientiert sich an Altersfreigaben aus der Filmwelt: Inhalte für Teenager unter 18 Jahren werden künftig strenger gefiltert. Eltern erhalten mehr Kontrolle. Zunächst in vier Ländern, ab 2026 auch in Europa und Deutschland.

Mit Uniqlo, Søstrene Grene und Arket ist die Biebergasse an der Hauptwache wieder komplett. Weitere Neueröffnungen internationaler Marken stehen an. Wer schon da ist, investiert in modernere und größere Filialen.

Der Billigflieger legt mit seinen Kürzungen in Deutschland nach und zieht Flugzeuge ab. Besonders trifft das den Berliner Flughafen. In anderen Ländern expandiert Ryanair nun stärker.

Trainer weg, Liga offen, Stadion unklar – Frankfurt Galaxy steht nach dem Austritt aus der European League of Football vor einem komplizierten Neustart. Der Sportdirektor bezieht Stellung.